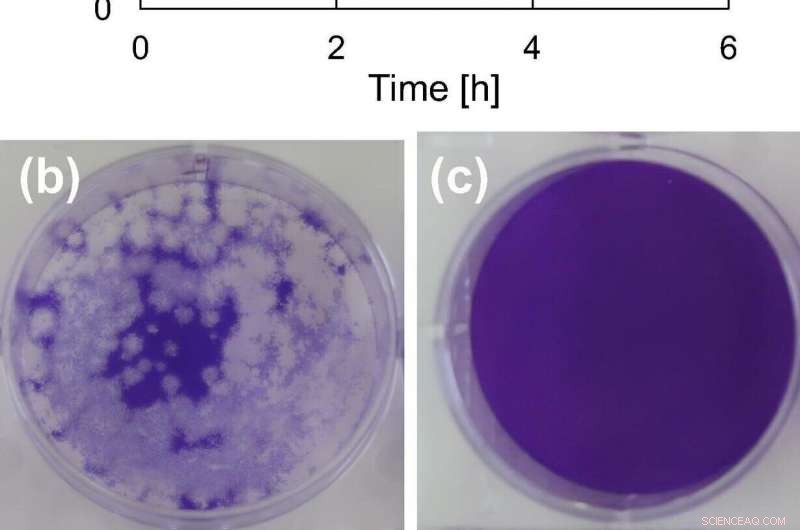
Materials Science Innovations to Combat COVID-19

(a) Antiviral activity of prepared powders against coronavirus and photographs showing the change in plaque number of coronavirus after four hours: (b) control and (c) with CMO. Credit: Material letters
Researchers at Tokyo Institute of Technology working in collaboration with colleagues at the Kanagawa Institute of Industrial Science and Technology and Nara Medical University in Japan have succeeded in preparing a material called cerium molybdate (γ-Ce2Mo3O13 or CMO), which exhibits high antiviral activity against coronavirus.
The ongoing coronavirus pandemic has highlighted the urgency not only of vaccine development and rollout but also of developing innovative materials and technologies with antiviral properties that could play a vital role in helping to contain the spread of the virus.
Conventional inorganic antimicrobial materials are often prepared with metals such as copper or photocatalysts such as titanium dioxide. However, metal-based materials can be prone to corrosion, and the effects of photocatalysts are usually limited under dark conditions.
Now, a research team led by Akira Nakajima of Tokyo Institute of Technology's Department of Materials Science and Engineering proposes a new type of an antiviral material that can overcome these drawbacks. The team successfully combined a relatively low-cost rare earth element cerium (Ce) with molybdenum (Mo), which is well known for its antibacterial effects, to prepare two types of cerium molybdate (Ce2Mo3O12 and γ-Ce2Mo3O13) in powder form.
Both powders exhibited antiviral activity against bacteriophage Φ6. Notably, γ-Ce2Mo3O13 also exhibited high antiviral activity against SARS-CoV-2, the virus that causes COVID-19.

Credit: Material Letters
The researchers infer that an effective combination of cerium with the molybdate ion as well as the specific surface area are key factors contributing to the observed antiviral activity.
The study builds on earlier work led by Nakajima which demonstrated the antiviral activity of a material named LMO (La2Mo2O9), composed of lanthanum (La) oxide and molybdenum oxide. LMO's activity, however, was found to be better against non-envelope-type (bacteriophage Qβ) than against envelope-type (bacteriophage Φ6) viruses. Subsequent tests showed that incorporating cerium into the material to make La1.8Ce0.2Mo2O9 (LCMO) improved antiviral activity against bacteriophage Φ6. It was this remarkable finding that spurred further investigations into cerium molybdates (CMO) as promising materials with high antiviral activity against envelope-type viruses such as influenza and SARS-CoV-2.
To obtain the desired CMO powder samples with an almost single-crystal phase, the team conducted many trial experiments before successfully preparing Ce2Mo3O12 using the polymerizable complex method and γ-Ce2Mo3O13 through hydrothermal processing.
If standardized and mass-produced, CMO could be used in a wide range of materials such as resins, paper, thin films and paints. This would open up the possibility of using CMO coatings for high-contact surfaces such as door handles, straps inside vehicles, elevator buttons and escalator belts as well as walls, tiles and windows. Nakajima envisions that materials incorporating CMO could also be used in everyday items such as smartphones and clothing. He notes that applications for eye and face ware such as glasses and masks may take a little longer time to develop, but be on the horizon.